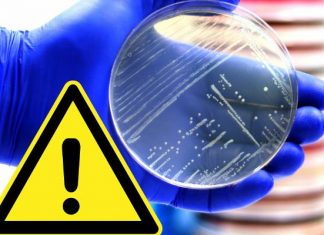
Śmiertelna bakteria w żywności dla dzieci. GIS wycofał produkt z Listerią, spożycie zagraża najbardziej właśnie najmłodszym

Ruszył pilotaż antykoncepcji awaryjnej. MZ ogłosiło rozporządzenie. Kiedy tabletka „dzień po”...
Pilotaż antykoncepcji awaryjnej wszedł w życie z dniem 1 maja 2024 r. Tabletka „dzień po” przysługuje teraz osobom od 15. roku życia na podstawie...
Dodatkowe opłaty w szpitalach. Oto lista rzeczy, za które trzeba dopłacić...
Dodatkowe opłaty w szpitalach. Oto lista wydatków, które poniesiemy w placówce medycznej. Pobyt w szpitalu to nic przyjemnego, a zdarza się, że trzeba tam...
Zmiany w skierowaniach na wyjazd do sanatorium w 2024 roku. Zobacz...
Spore zmiany dla chorych, którzy chcą wyjechać do sanatorium. Od 5 marca 2024 r. zaczęły obowiązywać nowe przepisy dotyczące leczenia uzdrowiskowego. Ministerstwo Zdrowia opublikowało...
Śmiertelna bakteria w żywności dla dzieci. GIS wycofał produkt z Listerią,...
Żywność dla najmłodszych dzieci powinna być najwyższej jakości, tymczasem w jednej z partii popularnego produktu wykryto niezwykle niebezpieczną bakterię. Spożycie grozi zapaleniem opon mózgowych...
Nowe ostrzeżenia GIS i GIF. Te produkty wycofano ze sklepów: Biedronka,...
Nowe ostrzeżenie GIS, aktualne na dzień 1.05.2024! Oto lista produktów, które zostały wycofanych przez sklepy sieci: Biedronka, Lidl, Netto, Kaufland, POLOmarket, Auchan. Sprawdź...
Zmiany w skierowaniach na wyjazd do sanatorium w 2024 roku. Zobacz...
Spore zmiany dla chorych, którzy chcą wyjechać do sanatorium. Od 5 marca 2024 r. zaczęły obowiązywać nowe przepisy dotyczące leczenia uzdrowiskowego. Ministerstwo Zdrowia opublikowało...